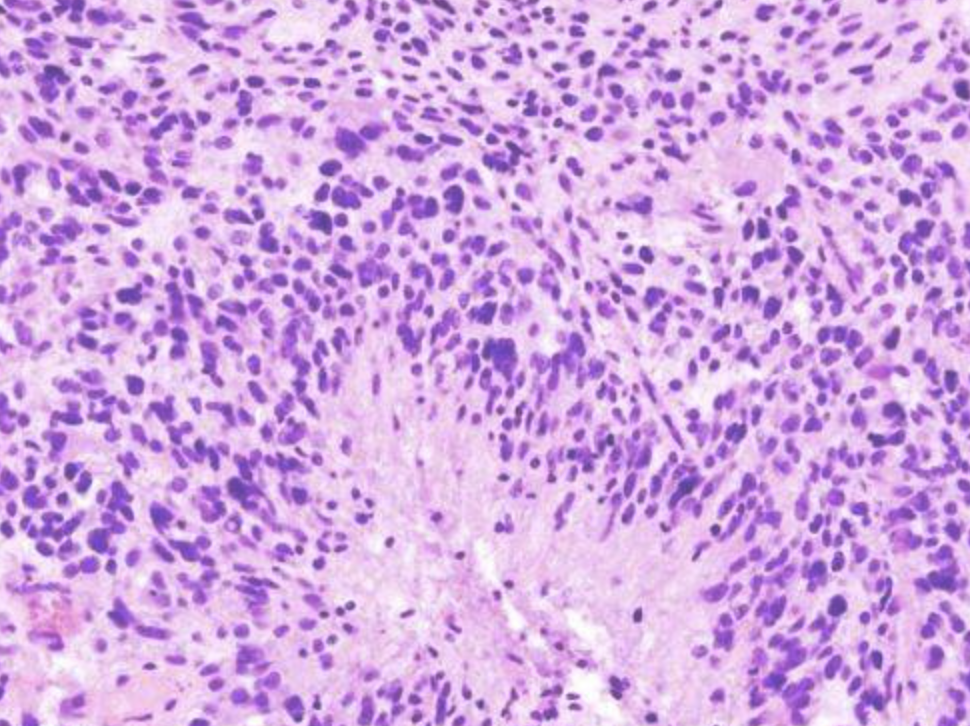

Cancer Exhibits a Distinctive Nuclear Metabolic Signature
Blood Tests Could Revolutionize Early Cancer Detection – But There's a Catch
What Changed Immunotherapy in Bladder Cancer
Breakthrough Could Lead to More Effective Treatments for Colon Cancer, Other Gut Diseases
Unraveling the secrets of telomerase, an enzyme linked to aging and cancer
Common blood pressure drug can boost cancer treatment
How inflammation may prime the gut for cancer
Major Cancer Breakthrough Could Help Patients Who Don’t Respond to Immunotherapy
Light-activated nanoparticles trigger copper overload to kill cancer cells
Scientists discover why cancer drugs don’t work for everyone
Engineering NK and T cells with metabolite-sensing receptors to target solid tumors
A protein may help revive exhausted T cells in cancer immunotherapy
Previously unrecognized immune response could enhance defense against cancer
Cancer’s Deadly Paradox: How Tumors Break Their Own DNA To Keep Growing
Nanoparticles Derived from Tea Leaves Kill Lung Cancer Cells
Dual Immunotherapy Eliminates Tumors in Animal Cancer Models
Revolutionary New Cancer Treatment Reprograms Immune Cells Inside the Body
New Experimental Drug Shrinks Tumors in Prostate Cancer Clinical Trial
HPV-positive cancers hide from the immune system, but blocking a single protein could make the tumors treatable
A lysosome switch could reshape research on cancer and neurodegenerative disease
AI Strategy Could Eliminate Radiologist Review of Low-Risk Mammograms
Scientists turn probiotic bacteria into tumor-hunting cancer killers
Gum disease bacterium linked to breast cancer growth and spread
Macrophages restrict tumor immune infiltration by controlling collagen topography
Cancer vaccines could transform treatment and prevention – but misinformation about mRNA vaccines threatens their potential
Meet the man who designed a cancer vaccine for his dog
Prodrug lipid nanoparticle could unlock universal immunotherapy for solid cancers
Thymus May Be Critical for Longevity and Cancer Immunotherapy Response
US proposes easing limits on cancer-causing gas used to clean medical devices
Vaccine Cuts Risk of Common Cancer For Decades, Major Study Finds
Ultrasound-based approach to delivering potent drugs into cancer cells shows promise in benchtop experiments
Severe COVID or flu may raise lung cancer risk years later
Scan that makes prostate cancer glow reduces need for invasive tests
Deep-sea natural compound targets cancer cells through a dual mechanism
New Pancreatic Cancer Treatment Wipes Out Tumors and Blocks Drug Resistance
Breakthrough Senolytic Therapy Offers New Hope for Pancreatic Cancer (PDAC)
Cats May Hold the Key to Treating Human Cancer
Does Being Vegetarian Reduce Your Risk of Cancer?
A New Type of Immunotherapy Drug for Prostate Cancer Shows Up to 99% Drop in Cancer Biomarkers
Scientists discover molecule that stops aggressive breast cancer in its tracks
Chromosomal instability shapes the tumor microenvironment of esophageal adenocarcinoma via a cGAS–chemokine–myeloid axis
How to Help Friends Dealing With Cancer
Half dose of prostate drugs ‘controls cancer without severe side effects’
The Guardian view on cancer survival rates: there is good news about healthcare amid the gloom
Mushroom Consumption May Reduce Risk of Cancer
Flavonoid-Rich Diet Protects against Cancer and Heart Disease, Study Says
Compound Found in Congolese Liana Starves Pancreatic Cancer Cells
Baking Soda Could Improve Cancer Therapy
New AI Model Predicts Cancer Spread With Incredible Accuracy
Breakthrough Discovery Could Make Pancreatic Cancer Respond to Chemo Again
A Simple Dietary Supplement Could Make the Difference Between Life and Death During Illness
Molecule Discovered To Fuel Skin Cancer and Outsmart the Immune System
Vegetarians have ‘substantially lower risk’ of five types of cancer
Scientists discover the enzyme that lets cancer rapidly rewire its DNA
New iron nanomaterial wipes out cancer cells without harming healthy tissue
Hard-to-Treat Cancers Have a Secret Trick That Researchers Finally Cracked
Hidden Virus Found in Gut Bacteria Is Linked to Colorectal Cancer
Researchers praise ‘stunning’ results of new prostate cancer treatment
One stem cell generates 14 million tumor-killing NK cells in major cancer breakthrough
Cancer blood tests are everywhere — here's why you should be cautious
Scientists Crack a 50-Year Tissue Mystery With Major Cancer Implications
As CAR-T cell therapy gains ground on solid tumors, regulatory red tape hinders progress
An existing, FDA-approved drug could stem the spread of breast cancer
Cracking a ‘holy grail’ challenge in cancer cell therapy
Scientists Rewire Natural Killer Cells To Attack Cancer Faster and Harder
Vitamin B7 reveals a new metabolic weak spot in some cancers
Scientists engineer bacteria to eat cancer tumors from the inside out
Scientists find the genetic switch that makes pancreatic cancer resist chemotherapy
Proximity to US nuclear plants linked to 115,000 cancer deaths since 2000
A new milestone in the cancer fight: 7 in 10 patients now survive five-plus years
Seven million cancers a year are preventable, says report
New Treatment Wipes Out Cancer Cells Without Harming Healthy Tissue
How lung tumors use the brain to avoid immune attacks
The true story behind Mariano Barbacid’s ‘first effective therapy against pancreatic cancer’
Scientists Find a Sneaky Way To Starve Cancer Cells Without Harming Healthy Cells
X-ray activated platinum complex induces DNA damage and enhances cancer immunotherapy through abscopal effect
A genetic blueprint for avoiding killer T cell exhaustion
This Forgotten Cancer Vaccine’s Results Were So Unusual Scientists Revisited It 20 Years Later
Low Midlife PSA Linked to Reduced 20-Year Prostate Cancer Risk
Scientists Supercharge HPV Cancer Vaccine With a Tiny Structural Shift
Experimental bioadhesive patch sticks to wet brain tissue and wipes out most glioblastoma cells
Growth of spreading pancreatic cancer is fueled by 'underappreciated' epigenetic changes, shows study
Let’s get on pancreatic cancer’s nerves
CRISPR Meets Caffeine: Scientists Develop New Approach to Cancer Treatment
Why colorectal cancer breaks the immune system’s rules
New triple-drug treatment stops pancreatic cancer in its tracks, a mouse study finds
Innovative CAR-T therapy destroys cancer cells without dangerous side effects
Toxin Stops Colon Cancer Growth, Without Harming Healthy Tissue
Study Finds Dietary Supplements and Probiotics Slow Prostate Cancer Progression
Researchers Discover Brain Cancer’s Secret Helpers – and How To Shut Them Down
Moderna’s Skin Cancer Vaccine Is Looking Seriously Promising
Common Plastic Chemical Found To Feminize Males and Masculinize Females
Researchers Discover New Way To Wake Up Cancer-Killing T Cells
A Common Pain Relief Drug Could Have Anti-Cancer Properties
Multi-omics profiling of cachexia-targeted tissues reveals a spatio-temporally coordinated response to cancer
An oral cancer drug shows promise against aggressive brain tumors
Colon cancer is now the deadliest cancer for young adults
Pancreatic Cancer Sends Secret Signals That Sabotage Immune Cells
Bone cancer therapy unexpectedly makes tumours less painful
Scientists Discover Brain Cancer Begins in “Normal” Cells Long Before Tumors Appear
New “Cancer Flashlight” Could Reveal Who Truly Benefits From Targeted Treatments
CD4+ T cells mediate CAR-T cell-associated immune-related adverse events after BCMA CAR-T cell therapy
Israeli hospital's 'groundbreaking' studies could lessen treatments, reduce prostate cancer risks
Fine-tuning BACH2 dosage balances stemness and effector function to enhance antitumor T cell therapy
A new strategy to beat lung cancer: Chemists develop first-in-class inhibitor targeting a key epigenetic regulator
Generating helper T cells from stem cells
Drug costing just £2.50 will extend life of prostate cancer patients
Optimal murine CD4+ T cell priming by mRNA-lipid nanoparticle vaccines requires endogenous antigen processing
ImmunityBio Announces Durable Complete Response of 15 Months with a Chemotherapy-Free CD19 CAR-NK Cell Therapy in Waldenstrom Lymphoma
Microbiota-induced T cell plasticity enables immune-mediated tumour control
5-methylcytosine and 5-hydroxymethylcytosine are synergistic biomarkers for early detection of colorectal cancer
Simple supplement mix shows remarkable results in brain cancer
Why cancer can come back years later — and how to stop it
Potential Anti-Cancer Fungal Compound Finally Synthesized After 55 Years
Injection turns sleeping tumor immune cells into cancer fighters
Short-circuiting pancreatic cancer
Turns Out This Common Supplement May Help Protect Against Colon Cancer, Too
Scientists Found a Way to Supercharge the Immune System Against Cancer
Could a Simple Nasal Drop Treat the Deadliest Brain Cancer?
Immunosuppressive mechanisms and therapeutic interventions shaping glioblastoma immunity
Yibin Kang’s team identifies new path to potential cancer treatments
Magnetic nanoparticles fight bone cancer and help healing
SLC2A1+ tumour-associated macrophages spatially control CD8+ T cell function and drive resistance to immunotherapy in non-small-cell lung cancer
The Immune Cell Scientists Couldn’t Grow Until Now Could Change Cancer Treatment
Unveiling Predictive Cancer Therapy Biomarkers via Computation
Immuneering’s pancreatic cancer pill continues to beat standard care, updated first-line data show
Natural compound supercharges treatment for aggressive leukemia
Alcohol-linked DNA damage tied to cancer risk: Study reveals repair enzyme's role
This Common Drug Seems to Fight One of The Deadliest Brain Cancers
New Antibody Treatment Reawakens Immune System To Fight Pancreatic Cancer
Scientists Unveil Breakthrough Method to Mass-Produce Cancer-Fighting Natural Killer Cells
Mystery Solved: Scientists Discover Why Colorectal Cancer Defies Immune System Rules
A rare cancer-fighting plant compound has finally been decoded
Cancer cells depend on a dangerous DNA repair trick
Nerve Damage Can Disrupt Immunity Across the Entire Body
TGF-β builds a dual immune barrier in colorectal cancer by impairing T cell recruitment and instructing immunosuppressive SPP1+ macrophages
High-fiber diet may 'rejuvenate' immune cells that fight cancer, study finds
Scientists Solve Pancreatic Cancer Mystery: Key Driver of Unusually Deadly Spread Identified
Arvin George, MD, highlights VAPOR 2 trial of thermal water therapy for prostate cancer
Scientists create ‘immune-activating’ molecule to help the body fight cancer
Study reveals tumor defense mechanisms in colorectal cancer
The hidden “Big Bang” that decides how bowel cancer grows
The origin of hepatocellular carcinoma depends on metabolic zonation
Prostate Cancer Patients Offered Fresh Hope by Promising New Drug Combination
Duke Health researchers announces breakthrough in breast cancer vaccine trial
Serotonin Could Play an Unexpected Role in Cancer, Scientists Discover
Bacterial Traces Within Brain Tumors Could Influence Tumor Behavior
One, two, many: how many cells start a tumour?
Tiny Metal Nanodots Obliterate Cancer Cells While Largely Sparing Healthy Tissue
Antibody halts triple-negative breast cancer in preclinical models
New bacterial therapy destroys cancer without the immune system
AI Finally Takes On a Century-Old Cancer Mystery
This Common Drug Seems to Fight One of The Deadliest Brain Cancers
Nasal Drops Could Help Fight a Common And Deadly Brain Cancer
Why important genes 'go quiet' as we get older
Genomic Insights Define Prognostic Mantle Cell Lymphoma Subtypes
A New Way To Stop Cancer Growth: Groundbreaking Drug Enters Human Trials
New Drug Kills Cancer 20,000x More Effectively With No Detectable Side Effects
This common liver supplement could boost cancer treatment success
MIT Research Shows How Diet Influences Colon Cancer
Vitamin C Supplements Could Help Reduce Toxic Side Effects of Common Cancer Treatment
Yale Researchers Develop Method to Attack Cancer at Its Source
They found the switch that makes the body attack cancer
Are cancer surgeries removing the body’s secret weapon against cancer?
Scientists “Completely Eliminate” Leukemia in Preclinical Model
Researchers engineered cells that destroy tumors and evade the immune system — major breakthrough
Scientists Strip Cancer of Its “Superpower” To Outsmart Drugs
COVID-19 mRNA vaccines can trigger the immune system to recognize and kill cancer, research finds
Epigenetic regulation of T cell exhaustion in cancer
Uprooting Cancer: Innovative Hydrogel Rapidly Reverts Cancer Cells Back to Cancer Stem Cells
New Research Shows Cellular Clean-Up Can Also Sweep Away Forms of Cancer
Research finds COVID-19 mRNA vaccine sparks immune response to fight cancer
Cancer Immunotherapy Treatment 2.5x More Effective With Mitochondrial DNA Mutations
Chemical linked to low sperm count, obesity and cancer found in dummies, tests find
Breakthrough Proton Therapy Wipes Out Rare Cancer With No Side Effects
Mayo Clinic uncovers hidden driver fueling aggressive prostate cancer
Scientists Find a Way to “Bulletproof” T Cells Against Cancer
Scientists just cracked the mystery of why cancer immunotherapy fails
The immunology of brain tumors
Certain dietary fatty acids can supercharge cancer-fighting immune cells
Breakthrough Blood Test Detects Head and Neck Cancer up to 10 Years Before Symptoms
Very common virus found to drive cancer growth by hijacking cells
New Research Challenges Long-Standing Method For Treating Cancer
Decoding ferroptosis for cancer therapy
A common supplement could supercharge cancer treatments
Novel immune system boost helps fight cancer cells
Scientists Discover Cancer’s “Power-Up” – and a New Way To Switch It Off
DOLPHIN AI uncovers hundreds of invisible cancer markers
New study shows how cancer tricks the immune system with the help of a hormone
‘Molecular glue’ harnesses the power of the immune system to treat neuroblastoma
Lipids found to play key role in immune process for clearing dead cells and microbes
Cancer uses mitochondria to reprogram neighboring cells
Key driver of pancreatic cancer spread identified
A hormone that silences the immune system may unlock new cancer treatments
Fructose and glucose from sugary drinks enhance colorectal cancer metastasis via SORD
Dietary supplement found effective for skin cancer prevention
Breakthrough stem cell therapy could provide permanent cancer immunity
Just4Kids: Why is heart cancer so rare? A biologist explains
Discovering a Vital Link Between Iron Metabolism and Melanoma Plasticity
This Widely-Used Antidepressant Could Be a Powerful New Weapon Against Cancer
Challenging Over 150 Years of Immunotherapy: Scientists Unveil New Weapon That Kills Cancer Without the Immune System
Targeting mitochondria: restoring the antitumor efficacy of exhausted T cells
New cancer test can warn patients up to 10 years before treatment is needed
From pancreatic to colorectal: 10 deadliest cancers in the world by survival rate
Scientists Strip Cancer of Its “Superpower” To Outsmart Drugs
UK biotech to trial cancer treatment based on ‘super donor’ immune cells
Russia's Enteromix Cancer Vaccine Shows 100% Efficacy In Early Trials
Cells “vomit” waste in a hidden healing shortcut that could also fuel cancer
Plant-based nutrient can boost immune cells' ability to fight cancer
A common supplement could reverse the hidden harm of sucralose
Nutrient found in beef and dairy improves immune response to cancer: Study
Depriving brain tumours of an amino acid could enhance chemotherapy
Studies deliver new blow to cancer microbiome literature—and offer a way forward
Rewiring of cortical glucose metabolism fuels human brain cancer growth
Customizable protein helps body remove harmful cells, offering hope for cancer and autoimmune diseases
mRNA vaccine power enhanced for cancer and autoimmune disease prevention
Genomic study of triple-negative breast cancer in African American women reveals disease not linked to ancestry
Tropical Fruit Molecule Could Revolutionize Liver Cancer Treatment
Popular Artificial Sweetener Could Sabotage Cancer Treatment, Study Warns
IgM and IgG1 B cell receptors differentially affect B cell fates and dictate the pathogenesis of mature B cell lymphomas
Dandelion root extract affects colorectal cancer proliferation and survival through the activation of multiple death signalling pathways
Experimental drug eliminates aggressive breast, skin cancer in small trial
New mRNA Cancer Vaccine Delivers Stunning Results, Sparks Universal Treatment Hopes
Mitochondrial antioxidant found to drive breast cancer metastasis
Synthesis of a molecule found in guava plants offers hope in fighting liver-related cancers
This Tiny Genetic Glitch Is Crippling Some of the Deadliest Cancers
The oncogene SLC35F2 is a high-specificity transporter for the micronutrients queuine and queuosine
'Universal' cancer vaccine heading to human trials could be useful for 'all forms of cancer'
Bee Sting Venom as a Viable Therapy for Breast Cancer: A Review Article
The 30-minute workout that could slash cancer cell growth by 30%
Bacterial duo eliminates tumors without immune system help in new cancer therapy
Concerns Emerge Over Potential Cancer Links to Drugs Like Ozempic
Targeting sleeping tumor cells: Oncogene location may determine neuroblastoma's resistance to cancer therapy
CT Scans Projected to Result in 100,000 New Cancers Across The US
New molecular technology targets tumors and simultaneously silences two 'undruggable' cancer genes
Researcher who studied CANCER for 30 years shares 6 simple tips to reverse it
Mushroom-derived molecule drives microbial chemistry linked to colorectal cancer
Israeli Researchers Find a Way to Reprogram Immune Cells to Target Cancer
The 0.05% RNA Process That Makes Cancer Self-Destruct
Common Viruses May Wake Dormant Breast Cancer Cells, Study Finds
Breakthrough lung cancer treatment supercharges immune cells with mitochondria
This Virus Doesn’t Make You Sick. It Makes You Stronger
Scientists discover a molecular switch to turn cancer cells into normal cells
Prostate Imaging for Recurrence Reporting: User Guide
Scientists identify shared biological roots of long COVID and chronic fatigue syndrome
‘Universal’ Cancer Vaccine Shows Stunning Results In Mice And Dogs
The Gene That Turns Sunshine Into a Cancer Killer
New synthetic molecule targets and kills breast and pancreatic cancers in as few as three doses
Hormone found to suppress immune cells, allowing cancer to evade detection
Cancer cells go up in flames—thanks to this deep-sea sugar
The plant virus that trains your immune system to kill cancer
New Cancer Drug Blocks Tumors Without Debilitating Side Effects
Early-Onset Gastrointestinal Cancers
Kitchen Bacteria + Stevia = Breakthrough Pancreatic Cancer Fighter, Study Finds
Viome and Scripps Research join forces to develop at-home RNA test for colon cancer prevention
Scientists 3D print tumors for cancer research — TissueTinker using 3D bioprinting to create miniature models of healthy and diseased tissue for side-by-side comparison, backed by McGill
Cancer death rates are falling
It is time to be optimistic about cancer
Description goes here
Isolated gut microbe drives stronger responses to cancer therapy
Chinese study uncovers cancer-fighting potential of impotence drugs like Viagra
https://www.scmp.com/news/china/science/article/3316838/chinese-study-uncovers-cancer-fighting-potential-impotence-drugs-viagra
Energy Drinks Seen Fuelling Cancer, But There's a Strange Catch
A new “link” to triple-negative breast cancer
Supercharged T Cells: A New Way To Kill Pancreatic Cancer With Minimal Side Effects
Johns Hopkins Researchers Uncover a New Way To Kill Cancer Cells
Liquid biopsy-based multi-cancer early detection: an exploration road from evidence to implementation
New ‘drug-factory’ implants successfully kill many types of cancer, study finds
South Korean Scientists at KAIST Reprogram Colon Cancer Cells in Breakthrough That Could Change Oncology
Scientists Just Found a Troubling Link Between Energy Drinks and Cancer
Antibiotics and energy inhibitors effectively kill aggressive melanoma cells by blocking mitochondrial pathways
HMGA2 and protein leucine methylation drive pancreatic cancer lineage plasticity
Doctors sound alarm as over-the-counter drug taken by millions is linked to CANCER
Menopause Drug Reduces Breast Cancer Growth In Clinical Trial
The tumor microenvironment’s role in the response to immune checkpoint blockade
Computational tool exposes hidden cancer DNA changes that may drive treatment resistance
Simple blood test detects cancer up to 3 years before symptoms appear
A Forgotten Cancer Is Surging in Young People, And Experts Are Puzzled
J&J ties early-stage lymphoma CAR-T to 100% response rate in 10 patients
Removing a cancer-activated cell type is shown to virtually eliminate liver metastasis
Targeting lactylation reinforces NK cell cytotoxicity within the tumor microenvironment
Satri-cel study marks first randomized CAR T-cell success in solid tumors
Development and validation of an autonomous artificial intelligence agent for clinical decision-making in oncology
Study shows loss of Y in blood cells hinders immune response to cancer
Australia’s bowel cancer rates are world’s highest for under-50s. Scientists wonder if the gut microbiome is to blame
Immunotherapy trial helps cancer patients with tumours live 40% longer
The gut microbiome as a target in cancer immunotherapy: opportunities and challenges for drug development
How soy and gut microbes alter cancer treatment results
Gut bacteria may hold key to unlocking better cancer treatment
The landscape for radioligand therapies in oncology
The mysterious stem cells that could hold the key to beating bowel cancer
How Apigenin May Reduce Senescence and Cancer
Scientists discover unexpected factor that could increase cancer risk in children: 'Cancer could potentially be influenced by events in early life'
Supercharged Antibodies: Scientists Engineer Potent New Weapon Against Cancer
CXCR4+ mammary gland macrophageal niche promotes tumor initiating cell activity and immune suppression during tumorigenesis
T cell cytokines found to influence tumor-immune interactions in metastases
This 100-year-old treatment could revolutionize the fight against breast cancer.
Experts sound alarm over cancer-causing chemicals hidden in food packaging - even 'eco-friendly' containers are a risk
Common Energy Drink Ingredient Linked to Blood Cancer
Breakthrough Proton Therapy Wipes Out Rare Cancer With No Side Effects
New Biomarkers of Treatment Resistance in Metastatic Prostate Cancer Found
Scientists develop a ‘metal detector’ to find cancer’s weak points
A New Immune Treatment May Work Against Several Cancer Types
Scientists Unveil Breakthrough Urine Test That Beats PSA in Spotting Prostate Cancer
A new type of super-strong antibody could boost immune systems of cancer patients
How protein-slayer drugs could beat some of the cruellest cancers
Glioblastoma Vaccine Trial Moves Forward
Mayo Clinic Doctor Reveals 3 Simple Ways To Reduce Your Risk of Head and Neck Cancer
Your Gut Might Be the Key to Preventing Blood Cancer, New Research Reveals
New Hope: Memory-Enhanced NK Cells Could Revolutionize Cancer Treatment
mRNA technology helps reinvigorate the hunt for cancer vaccines
p53 protein degradation redefines the initiation mechanisms and drives transitional mutations in colorectal cancer
Four rising stars at the forefront of cancer research
Cells are swapping their mitochondria. What does this mean for our health?
Smart T-Cells Built to Last: Ultrasound-Activated Cancer Killers Target Solid Tumors
He had 2 months to live. Cancer research "that seemed like science fiction" saved his life.
T-bet+CD8+ T cells govern anti-PD-1 responses in microsatellite-stable gastric cancers
Blocking Erythropoietin Signaling in Mice Converts Liver Tumors into Immunotherapy Responders
Lifesaving new vaccine protects against multiple types of cancer
Breakthrough breast cancer vaccine stops tumors before they start
Immune Resilience Identified as Key to Healthy Aging and Longevity
Scientists Discover Unexpected Link Between Diet And Lung Cancer Risk
Targeting PIKfyve-driven lipid metabolism in pancreatic cancer
Scientists May Have Found a Secret Weapon To Stop Pancreatic Cancer Before It Starts
Cancer-Causing Arsenic Is Building Up in the World’s Rice
The Mere Thought of Being Hungry Could Alter Your Immune System
Shared Protein Link Found Between Parkinson’s and Cancer
Gut commensal Bifidobacterium-derived extracellular vesicles modulate the therapeutic effects of anti-PD-1 in lung cancer
This Tiny Cellular Gate Could Be the Key to Curing Cancer – And Regrowing Hair
Tumor byproduct blocks immune cells from fighting cancer, offering new treatment target
New Drug Delivery Tech Could Change How We Treat Cancer and Alzheimer’s
Tattoos may be linked to an increased risk of cancer
Medical cannabis shows potential to fight cancer, largest-ever study finds
Breast cancer treatment advances with light-activated 'smart bomb'
How a low-carb diet can drive colorectal cancer development
Research identifies key enzyme target to fight deadly brain cancers
Eat better, breathe easier? Research points to link between diet, lung cancer
Key to the high aggressiveness of pancreatic cancer identified
Researchers identify DNA changes, biological pathways associated with inherited cancer risk
Long-Term Yogurt Consumption Tied to Decreased Incidence of Certain Types of Colorectal Cancer
Researchers investigate low-intensity electrical pulses to help the immune system fight cancer
Data from all 50 states shows early onset breast cancer is on the rise in younger women: Does place of exposure matter? List Item
Gene editing boosts immunotherapy
Overuse of CT scans could cause 100,000 extra cancers in US
CU Department of Surgery Research Finds ‘Watch and Wait’ Management of Rectal Cancer Post-Treatment is Effective and Avoids Surgical Complications
Rectal cancer clinical trials a 'game-changer'
Personalized Cancer Vaccine Proves Promising in a Phase 1 Trial at Mount Sinai
Non-Statin Cholesterol-Lowering Drug Linked to Lower Cancer Risk
Markey researchers help discover diet, lung cancer link
Oral Cancer Cases Are on The Rise, And Sugary Drinks Could Be to Blame
Scientists Discover How To Reactivate Cancer’s Dormant “Kill Switch”
Cancer’s “Master Switch” Blocked for Good in Landmark Study
DrBioRight 2.0: an LLM-powered bioinformatics chatbot for large-scale cancer functional proteomics analysis
Supercharged T-Cells Hunt Down the Hardest-to-Treat Cancers
Novel spatial immune-based risk prediction platform can predict hepatocellular carcinoma recurrence
Scientists discover how to reactivate cancer's molecular 'kill switch'
Regular Blood Donations May Trigger Beneficial Genetic Changes in Bone Marrow Stem Cells
Tumor “Stickiness” – Scientists Develop Potential New Way To Predict Cancer’s Spread
Researchers discover new pathway to cancer cell suicide
Two viruses link to prostate cancer: High-risk human papilloma virus found with Epstein Barr virus
Greenland sharks can live for 400 years without getting cancer, thanks to their DNA
Prolonged exposure to work-related stress thought to be related to certain cancers
Cancer cells eat themselves to survive
Drug more than doubles survival time for glioblastoma patients
Glioblastoma: New treatment attacks brain tumors from multiple angles
Scientists Crack 30-Year Cancer Mystery: New Discovery Could Revolutionize Radiotherapy
ImmuneLENS characterizes systemic immune dysregulation in aging and cancer
Aspirin prevents metastasis by limiting platelet TXA2 suppression of T cell immunity
Scientists Discover How Engineered Bacteria Supercharge the Immune System to Kill Cancer
RNA neoantigen vaccines prime long-lived CD8+ T cells in pancreatic cancer
Scientists Discover Alarming Rise in Advanced Prostate Cancer in California
Cancer treatments accelerate ageing
RNA neoantigen vaccines prime long-lived CD8+ T cells in pancreatic cancer
Scientists Discover Natural Compound That Stops Cancer Progression
Researchers investigate rare side effect of blood cancer immunotherapy
The Breast Cancer Classifier refines molecular breast cancer classification to delineate the HER2-low subtype
Scientists Uncover New Way Cancer Evades the Body’s Defenses
Design of high-affinity binders to immune modulating receptors for cancer immunotherapy
Challenging Peto’s Paradox: New Research Overturns 45-Year-Old Cancer Theory
Water influx kicks immune cells into action, research reveals
Breast cancer cases projected to rise by nearly 40 per cent by 2050, WHO warns
Study uncovers two inhibitors to halt metaplastic breast cancer progression
Study Reveals Light Exercise Slashes Cancer Progression Risks
Study Finds No Evidence CAR T-Cell Therapy Causes Secondary Cancers
Dogs exposed to household chemicals more likely to get cancer, study finds
New approach identifies reproducible volatile organic compounds for lung cancer diagnosis
Learning and actioning general principles of cancer cell drug sensitivity
Scientists find new biomarker that predicts cancer aggressiveness
Researchers find cancer's 'off-grid' power supply – and how to cut it
Scientists Uncover Cancer’s Earliest Warning Signs – Before You’re Even Born
Intrinsic electrical activity drives small-cell lung cancer progression
New Research Pinpoints Mechanism Behind MYC Protein Production in Cancer
Viral Protein May Optimize Off-the-Shelf CAR T Cell Therapy
AXL signaling in cancer: from molecular insights to targeted therapies
Cancer’s Secret Weapon? Scientists Solve 40-Year Filopodia Mystery
Blocking Tumor Growth Before It Starts
Reimagining cancer: Stanford Medicine magazine reports on advances in cancer science, prevention, care
Alternatives to traditional cancer treatment
Distinct immune cell infiltration patterns in pancreatic ductal adenocarcinoma (PDAC) exhibit divergent immune cell selection and immunosuppressive mechanisms
New research unlocks key to long-lasting immune response in cancer and chronic diseases
Implantation of engineered adipocytes suppresses tumor progression in cancer models
Can Scientists Throw a Wrench into Cancer’s Growth Gears?
This protein discovery may change the treatment of colon cancer
New Research Uncovers Long-Lived DNA Damage Linked to Cancer
The ultra-fast cancer treatments which could replace conventional radiotherapy
Study highlights potential of genomic tests for early stage prostate cancer
City of Hope: Making a profound difference as we pursue cancer cures at the speed of life
Peptide-coated nanoparticles achieve 98% drug loading, improving cancer treatment
Experimental Tool May Help Predict Risk of Breast Cancer Recurrence
Prostate cancer study reveals early radiation side effects predict future issues
One Year in Cancer Research and Much to Celebrate
Advances in Pancreatic Cancer Research
'Forever Chemicals' in US Drinking Water Linked to Cancer, Scientists Find
Bowel cancer prediction test for IBD patients 90% accurate
Clean energy is key to reducing lung cancer deaths
Urine-based test detects aggressive prostate cancer
Research Spotlight: Advances in Pancreatic Cancer Research and Key Insights from ASCO GI 2025
When ‘Cancer’ Gets in the Way of Treatment
‘Dark proteins’ hiding in our cells could hold clues to cancer and other diseases
Cervical cancer treatment breakthrough cuts risk of death by 40%
Rectal Cancer Disappears After Experimental Use of Immunotherapy, Now an FDA Designated Breakthrough Therapy
Tumour hypoxia in driving genomic instability and tumour evolution
Fitness and muscle strength could halve cancer patient deaths, study suggests
Immunotherapy approach shows potential in some people with metastatic solid tumors
I'm A Breast Cancer Doctor. Here's What I Didn't Know — Until I Was Diagnosed Myself.
Drinking Tea or Coffee Each Day Could Reduce Mouth And Throat Cancer Risk
The ‘year of cancer vaccines’ confirms we are living in a golden age of cancer research
Cancer cases rising for women and younger adults in US, report finds
Biomarker in liquid biopsy for lung cancer appears more accurate in predicting immunotherapy response than tumor biopsy
Newly discovered mechanism triggers immune response in cells with damaged DNA
Scientists find 'key' to potential breast cancer prevention and treatment
New AI tool uses routine blood tests to predict immunotherapy response for many cancers
Breakthrough mRNA vaccine reinvents pancreatic cancer treatment
Cooking oils under scrutiny: New study links common varieties to cancer risk
Breakthrough Discovery Reveals Hidden Flaws in Cancer Research Models
Cancer's frequent spread to the lungs is driven by important amino acid
Improving immunotherapies for kidney cancer
12 new breakthroughs in the fight against cancer
Clinical cancer research in the U.S. increasingly dominated by pharmaceutical industry sponsors
Breakthrough Single-Dose Drug Wipes Out Breast Tumors in Mice Without Side Effects
How Estrogens Trick the Immune System to Secretly Fuel Cancer Growth
Researchers Pinpoint Molecular Mechanism Behind Breast Cancer Risk
Yale Researchers Discover New Complexities Behind Drug Resistance
Scientists Develop a New Way to Deliver MicroRNAs for Cancer Treatment
Cavity Shaving Reduces the Risk of a Second Mastectomy
New Drug Combination Delays Breast Cancer Progression
Big breakthrough in medical treatment: Korean scientists find undo button that turns tumour cells into normal ones
New Solution for Metastatic Ovarian Cancer Based on Approach From Nearly a Century Ago Shrinks Tumors
Simple Dietary Supplement Could Supercharge Cancer-Fighting Immune Cellst
"100% successful" cancer drug gets landmark FDA approval
The Risk of Cancer Fades as We Get Older, And We May Finally Know Why
Scientists Destroy 99% of Cancer Cells in Lab Using Vibrating Molecules
Human genome mapping uncovers 50,000 mysterious DNA structures
Researchers Develop Groundbreaking Technology To Revert Cancer Cells Into Normal Cells
Engineered T cells could help patients overcome resistance to CAR T cell therapy
Concerning Findings: Microplastics in the Air Could Be Causing Cancer
A Cancer-Causing Virus Hiding in Millions of Americans
Russia claims breakthrough in cancer treatment with mRNA vaccine, free for patients by 2025
Scientists Have Discovered a Cancer “Fingerprint,” Revolutionizing Early Detection
Experimental drug that summons 'warriors of the immune system' shows early promise against non-Hodgkin lymphoma
Cooking oils and omega fats are linked to cancer
What we just found out about the possible tie between microplastics and cancer
Research reveals how fructose in diet enhances tumor growth
'Cancer ghosting' can be more painful than treatment, survivors say
Linus Pauling Was Right About Vitamin C for Cancer!
Lab-Grown Tumor Models Mirror Glioblastoma Treatment Response
Scientists Crack Cancer’s Hidden Defense With a Breakthrough Protein Discovery
Deadly Timekeeping: How Brain Tumors Use Your Body Clock Against You
High-Fiber Plant-Based Diet Found To Halt Progression of Incurable Blood Cancer
GDF-15 inhibitors show promise against hard-to-treat tumors in clinical trial
Melanoma survival linked to tumor thickness
Startling Findings: High-Fructose Corn Syrup Linked to Cancer Growth
Scientists Uncover Potential Origins of Breast Cancer in “Normal” Cells
Revolutionary Microrobots Shrink Tumors in Groundbreaking Study
Light-induced gene therapy disables cancer cells' mitochondria
The dawn of a new medicine: Researchers use the theory of evolution to fight cancer
Cancer patients often do better with less intensive treatment, research shows
Cervical cancer deaths have plummeted among young women, US study finds
Alarming Rise in Cancers of The Gut Linked With These Deadly Diets
Researchers discover possible key to enhance immunotherapy cancer treatment: certain anti-inflammatory drugs
Cancer. And then, paying for cancer treatment
Next-generation combination approaches for immune checkpoint therapy
Tumor cell death can backfire, strengthening cancer's defenses and limiting immunotherapy success
From food crops to cancer clinics: Lessons in extermination resistance
Psilocybin therapy offers relief from multiple psychiatric symptoms in cancer patients
12 new breakthroughs in the fight against cancer
New Research Sheds Light on a Surprising Connection Between COVID-19 and Cancer Regression
From Fatigue To Organ Failures: Challenges Every Cancer Survivor Faces Post-Treatment
Brain tumor research identifies source of glioma's deadly transformation
Immunotherapy after surgery helps people with high-risk bladder cancer live cancer-free longer
Immunotherapy approach shows potential in some people with metastatic solid tumors
Cervical cancer treatment breakthrough cuts risk of death by 40%
Gold-based drug slows cancer tumor growth by 82%, outperforms chemotherapy
How different types of bread impact cancer risk
Healthy women have cells that resemble breast cancer, study finds
New cancer diagnoses did not rebound as expected following pandemic
To Combat Cancer Treatment Resistance, Researchers Try Leveraging Evolution
UChicago scientists develop new nanomedicine approach to improve cancer treatment
AI tool 'sees' cancer gene signatures in biopsy images
White button mushroom extract may help slow progression of prostate cancer
Study May Have Good News for Patients With Early-stage Liver Cancer
Clinical cancer research in the U.S. increasingly dominated by pharmaceutical industry sponsors
Breast cancer research Treatment victories and remaining questions.
Re-engineering cancerous tumors to self-destruct and kill drug-resistant cells
Purdue researchers take inspiration from viruses to improve delivery of nucleic acid-based therapies to cancer cells
Scientists glue two proteins together, driving cancer cells to self-destruct
Researchers develop affordable, rapid blood test for brain cancer
A New Artificial Intelligence Tool for Cancer
Indian Institute of Science study reveals how cancer cells adapt while moving across tissues
Breast cancer rates increasing among younger women
Looking to Nature: Plant Research Shows Promise in Fight Against Certain Cancers
Researchers develop a new way to safely boost immune cells to fight cancer
Scientists identify a form of vitamin B6 as a means of engaging tumor-reactive immune cells
Can viruses cause cancer?
New Discovery Reveals How Ovarian Cancer Starves Immune Cells
Surge in global cancer by 2050 with widening disparities projected by study
Novel principle for cancer treatment shows promising effect
Pest Management Strategies Adapted to Treat Drug-Resistant Cancers
Cancer Breathalyzer: Nanotech Breath Test for Cancer Could Save Lives
Virtual screening identifies potential small molecule drugs for cancer immunotherapy
Uprooting Cancer: Innovative Hydrogel Rapidly Reverts Cancer Cells Back to Cancer Stem Cells
Excess Weight Nearly Doubles a Woman’s Risk of Endometrial Uterine Cancer
CAR T-Cells Use SNIPR Technology to Confirm Cancer Targets before Firing
Stanford Scientists Overturn Mendel’s Law With Shocking Cancer Discovery
New Study Shows How Cancer Survivors Develop Opioid Addictions
New Evolution-Busting Drug Overcomes Resistance in Aggressive Breast Cancers
Blood Test Accurately Detects Over 50 Types of Cancer and Where It Originated, Often Before Any Symptoms
Researchers uncover new role of mutant proteins in some of the deadliest cancers
Peto’s Paradox – Biological Enigma Offers New Insights Into the Mystery of Cancer
New take on immunotherapy reinvigorates T cells by blocking uptake of energy-sapping cancer byproducts
Harvard Researchers Unveil an Unprecedented Look at Colorectal Cancer
Dairy Products Linked to Increased Risk of Cancer in Major Research Study
Glioblastoma: New treatment attacks brain tumors from multiple angles
“Astonishing” – Scientists Unveil First Blueprint of the Most Complex Molecular Machine in Human Biology
More young people are surviving cancer. Then they face a life altered by it
Breaking the Laws of Biology: Scientists Expose Cancer’s “Secret Weapon”
7 Years Before Diagnosis – Oxford Scientists Discover Key to Early Cancer Detection
Revolutionizing Cancer Detection: New Machine Learning Method Deciphers Genomic “Dark Matter”
Researchers uncover new role of mutant proteins in some of the deadliest cancers
Cell therapy fights lethal childhood brain cancer in Stanford Medicine trial
96% Accuracy: Harvard Scientists Unveil Revolutionary ChatGPT-Like AI for Cancer Diagnosis
Novel Vaccine Targets Deadly Brain Tumors with Precision
Clinical Trial: Mushroom Supplement May Halt Prostate Cancer Growth
Scientists Found A Clear Link Between Red Meat And Cancer Read More: https://www.bgr.com/science/scientists-found-a-clear-link-between-red-meat-and-cancer/
'Foam cells' that accelerate tumor growth in glioblastoma can be inhibited, researchers discover
High levels of omega-3, omega-6 may protect against cancer
Scientists Develop Fast, Affordable Cancer Test From a Single Drop of Blood
Startup gives surgeons a real-time view of breast cancer during surgery
BRCA only explains a fraction of breast cancers — genes tied to metabolism may also up risk
Metabolic Enzymes Go Nuclear, Paving the Way for Breakthrough Cancer Cures
Unlocking Cancer’s Code: Scientists Discover Six Critical Genes
Researchers discover cancer mechanism that can eliminate tumors—even those resistant to immunotherapy
NIH-funded scientists uncover clues to precancer and tumor biology
New Cancer-Fighting Structure Discovered in Liver Tumors Could Revolutionize Treatment
Novel immunotherapy combo shows promise in melanoma
Multifunctional antibody shows promise for treating several types of cancer
Lifesaving cancer study delivers complete remission for all trial patients
Doctors Have Identified 6 Epigenetic Hallmarks of Cancer
Amish have low cancer rate, but why?
Vitamin K supplement slows prostate cancer in mice, researchers discover
New lung cancer vaccine is a cousin of the mRNA vaccine that starred during COVID
Implantable microparticles can deliver two cancer therapies at once
Neu5Gc Sugar is Related to the Appearance of Spontaneous Tumors in Humans
Startling Discovery: Cancer Can Arise Without Genetic Mutations
Researchers Find a New Target to Treat a Wide Spectrum of Cancers
New Study Questions the Benefits of Mammograms
Startling: Humans Are Absorbing Microplastics, and It Is Increasing Our Risk of Cancer, Diabetes, and Heart Disease
Far Beyond Previous Estimates: Excess Body Fat Linked to 40% of Hormone-Positive Breast Cancer Cases
Unexpected immune response may hold key to long-term cancer remission
How does cancer hide from the immune system?
Spatial single-cell protein landscape reveals vimentinhigh macrophages as immune-suppressive in the microenvironment of hepatocellular carcinoma
Study finds estrogens play a hidden role in cancers, inhibiting a key immune cell
Spatial mapping of primary and metastatic pancreatic tumor ecosystems
Shocking Findings: Scientists Discover 200 Potential Cancer-Causing Chemicals in Everyday Food Packaging
Clinical cancer research in the US is increasingly dominated by pharmaceutical industry sponsors, study finds
Estrogens May Play a Hidden Role in Cancers
Alcohol plays key role in cancer risk, new expert report warns
Pancreatic Cancer: The Search for an Achilles Heel
What UVA Researchers Are Learning About Colorectal Cancer
Drilling Down to the Details in Cancer Research
To Combat Cancer Treatment Resistance, Researchers Try Leveraging Evolution
Researchers build first large-scale atlas of how immune cells react to mutations during cancer immunotherapy
Shielding the Brain: A Breakthrough in Preventing Cancer’s Spread
Scientists decode key mutation in many cancers, pointing to expanded role of RNA in human gene expression
This Incredibly Popular Diet Could Be Increasing Your Risk of Cancer
Breast cancer rising among younger women and Asian Americans, report finds
More younger people are getting colonoscopies, a new study suggests
New Report Links Alcohol to Six Major Cancer Types
Breast cancer-linked chemicals found in food packaging: Safety tips from experts
'These are people in the prime of life': The worrying puzzle behind the rise in early-onset cancer
Shocking Scientists: Toxic Cancer-Linked Plasticizers Found in Southern California Air
GLUT1 overexpression in CAR-T cells induces metabolic reprogramming and enhances potency
Researchers discover new ways to 'turn off' receptor involved in inflammatory diseases
Study Uncovers Mutations and DNA Structures Driving Bladder Cancer
The Biology of 'Precancer': Stopping Cancer Before It Starts
New study challenges longstanding assumption about the cause of the genome's most common mutation
The gut microbiome and dietary fibres: implications in obesity, cardiometabolic diseases and cancer
New computational pipeline revolutionizes personalized cancer vaccine design
Cancer risk slightly elevated in MS patients: 10-year study
Chronic stress disrupts gut bacteria and fuels cancer progression
Study suggests around 40% of postmenopausal hormone positive breast cancers are linked to excess body fat
Genetic mapping study uncovers four main categories of cancer drug resistance mutations
Op-ed: The financial toxicity of cancer is growing. Here’s what can be done to reduce it
New Cervical Cancer Treatment Regime Shows ‘Biggest Gain in Survival Since 1999’
A healthy diet may help keep low grade prostate cancer from progressing to more dangerous states
96% Accuracy: Harvard Scientists Unveil Revolutionary ChatGPT-Like AI for Cancer Diagnosis
Scientists Create a Potent Bacterial Anti-Cancer Vaccine
Genetic discovery paves the way for advanced pancreatic and colorectal cancer treatments
Re-engineered, blue light-activated immune cells penetrate and kill solid tumors
Study Explores Testosterone’s Paradoxical Effects in Prostate Cancer
New ChatGPT-like AI model could detect multiple different cancers, study finds
New Prostate Cancer Treatment Shows Promise in Preclinical Studies
Keto diet enhances experimental cancer therapy in mice
Immunotherapy approach shows potential in some people with metastatic solid tumors
Doubling Lifespan: Scientists Have Discovered a Key Cellular Mechanism That Could Control Longevity
Scientists Destroy 99% of Cancer Cells in Lab With Vibrating Molecules
Novel study reveals how aging immune system fuels cancer growth, potentially opening new avenues for prevention
Detailed data show Summit therapy beat Merck blockbuster Keytruda in late-stage lung cancer trial
Breaking the trend: Skin cancer incidence in young adults declines
5x Increase: USC Study Shows Cannabis Use Could Skyrocket Your Cancer Risk
China-US team creates plant-based nanoparticles to fight deadliest brain cancer
Women Will Be Notified of Breast Density After a Mammogram: What to Know
How the scars of demolished brain tumors seed relapse
Prostate cancer is being 'overdiagnosed' in Europe. Which countries see the biggest differences?
American Cancer Society warns about rise in late-stage prostate cancer
How the immune system fails as cancer arises
Five latent factors underlie response to immunotherapy
Study finds 'supercharging' T cells with mitochondria enhances their antitumor activity
Long-term metastatic melanoma survival dramatically improves on immunotherapy, clinical trial finds
China-US team creates plant-based nanoparticles to fight deadliest brain cancer
A new way to reprogram immune cells and direct them toward anti-tumor immunity
Moderna’s ‘Off-the-Shelf’ Cancer Vaccine Shows Promise in Early Human Trial Data
From new treatments to AI: advances in the fight against cancer
Toxic glass kills 99% of bone cancer without harming healthy cells
Deep Links Between Alcohol and Cancer Are Described in New Report
Report: Cancer diagnoses are more common but so is surviving
Black women are more likely than white women to die of all types of breast cancer
These Four Common Infections Can Cause Cancer
Scientists Just Identified Hundreds of Genes That Could Cause Cancer
A Sharper Focus on Increased Cancer Risks from Drinking Alcohol
A Common Culprit Drives Prostate Cancer Progression
Potential Cancer Breakthrough: Common Antidepressant Effective Against Brain Tumors
Study reveals how mutant p53 protein converts other proteins into cancer drivers
Childhood trauma linked to specific health risks
Mysterious Link Between Alzheimer's And Cancer May Finally Be Explained
New method uses nanoparticles to reprogram exhausted immune cells
Fighting Inflammation May Cause More Senescence
Fasting and ketogenic diet reveal new vulnerability of pancreatic tumors to existing cancer drug
Vitamin D deficiency linked to higher cancer mortality
New research gives unprecedented view of colorectal cancer genetic makeup
New targets for improved cancer immunotherapy
Study identifies metabolic switch essential for generation of memory T cells and anti-tumor immunity
Cancer patients' immune system gets in their own way, Washington University researchers find
These Cancers Are Most Impacted By Dietary Choices
Fasting's effects on stem cells linked to increased cancer risk
Colon-cancer risk in young people linked to one amino acid, small study finds
Dual-action therapy shows promise against aggressive oral cancer
New biomarker helps determine the optimal treatment for colon cancer
Grief Accelerates Biological Aging
Gut microbiota carcinogen metabolism causes distal tissue tumours
Gen X, millennials face higher risk of 17 cancers than older generations
New colorectal cancer blood test approved by FDA: What to know
Researchers develop promising therapy treatment that can kill glioblastoma cells in newly-discovered brain pathway
Drug bypasses suppressive immune cells to unleash immunotherapy
Sensory Neurons Play Role in Cancer Development
Eliminating a gut microbe could slash gastric cancers
Scientists are starting to uncover how neighborhood can affect the biology of cancer
Study Reveals Pesticides’ Cancer Risk Rivals That of Smoking
Epigenetic change to DNA associated with cancer risk in 'multi-omics' study
BCG Vaccine: A Breakthrough in Bladder Cancer Treatment
Ketogenic diet reshapes cancer metabolism through lysine β-hydroxybutyrylation
Heard of ductal carcinoma in situ or DCIS? What does Stage 0 breast cancer mean and how is it treated?
FSU researchers show potential of new treatment for pediatric brain cancer
Study of fasting and ketogenic diet reveals a new vulnerability of pancreatic tumors
Two new studies show how immunotherapies collaborate to boost T cell responses in melanoma
Stress Alters the Gut Microbiome Via Vagus Nerve Stimulation
NK cells expressing interleukin-21 show promising antitumor activity in glioblastoma cells
Newly Discovered Mechanism Could Significantly Improve Cancer Immunotherapies
CAR-T cell therapy’s complications, as well as its benefits, become clearer in ‘flurry’ of cancer studies
Immunotherapy approach shows potential in some people with metastatic solid tumors
Almost half of cancer deaths and 40% of cases caused by avoidable factors, new study finds
AI Cancer Detection 45 Times More Accurate Than Doctors, UCLA Says
Mitochondrial DNA mosaicism in normal human somatic cells
New Co-STAR T cells show promise for treating cancers in laboratory study
Tumor evolution metrics predict recurrence beyond 10 years in locally advanced prostate cancer
How guardian proteins change from inhibitors to promoters of cancer
Vitamin D Acts via the Microbiome to Boost Cancer Immunity
Scientists make DNA discovery that could help find pancreatic cancer cure
Metformin may help the immune system better identify breast cancer cells
Study shows ancient viruses fuel modern-day cancers
Study finds tumor growth fueled by nucleotide salvage
Scientists investigating explosion of colon cancers in young people make 'profound' discoveries about diet
Study Reveals Complexity of Mixed-Type Breast Cancers
Breast cancer study reveals a paradox of mastectomy
11 new breakthroughs in the fight against cancer
Kids From Poorer Families Less Likely to Survive Cancer
Pesticides May Raise Your Risk of Cancer as Much as Smoking
Study identifies two critical genes in pancreatic tumors
Ancient Genes of Zombie Viruses Revealed as Hidden Drivers of Cancer
Cell competition in primary and metastatic colorectal cancer
Nanoplastics and 'forever chemicals' shown to disrupt molecular structures and functionality
Harnessing Nutrients: Scientists Discover New Way To Effectively Treat Cancer
AI model finds the cancer clues at lightning speed
Serendipity reveals new method to fight cancer with T cells
How Melanoma Becomes Resistant to Treatment
Enhancing in situ cancer vaccines using delivery technologies
Bowel cancer turns genetic switches on and off to outwit the immune system, new study finds
New cancer treatment slows progression of aggressive neuroendocrine tumors, study finds
Destroying cancer-causing RNA could lead to bespoke treatments, say scientists
Why cancer risk declines sharply in old age
Faecal transplants can treat some cancers — but probably won’t ever be widely used
Re-engineering cancerous tumors to self-destruct and kill drug-resistant cells
Diabetes drugs like Ozempic lower cancer risks: Study
Using a pan-cancer atlas to investigate tumour associated macrophages as regulators of immunotherapy response
Reversing chemotherapy resistance in pancreatic cancer
Effect of diet on mortality and cancer recurrence among cancer survivors: a systematic review and meta-analysis of cohort studies
An updated systematic review and meta-analysis on adherence to mediterranean diet and risk of cancer
The Role of Diet in Prognosis among Cancer Survivors: A Systematic Review and Meta-Analysis of Dietary Patterns and Diet Interventions
Association between dietary fat intake and mortality from all-causes, cardiovascular disease, and cancer: A systematic review and meta-analysis of prospective cohort studies
Effect of Ketogenic Diets on Body Composition and Metabolic Parameters of Cancer Patients: A Systematic Review and Meta-Analysis
100% of cancer patients cured long-term in 'remarkable' human trial
The Effect of Cancer Trials on Their Participants
Lack of an immune receptor might prevent cancers associated with Epstein–Barr virus
Fasting supercharges the cancer-killing properties of immune cells
Combination targeted treatment produces lasting remissions in people with resistant aggressive B-cell lymphoma
New AI detects 13 deadly cancers with 98% accuracy from tissue samples
Resilience Linked to Healthier Brain and Gut
Gut microbiome discovery provides roadmap for life-saving cancer therapies
New blood test detects ovarian cancer years before conventional methods
Major breakthrough in the treatment of leukemia
Researchers design delivery system to guide drugs directly to cancer cells 'hiding' in bone marrow
Scientists reveal how an unstructured protein traps cancer-promoting molecules
Researchers discover incredible HULLK that controls prostate cancer progression
Research helps explain why androgen-deprivation therapy doesn't work for many prostate cancers
Compound shows promise as next-generation prostate cancer therapy
Gold nanoparticles kill cancer—but not as thought
Hybrid nanoparticles shine new light on targeting cancer cells
Possible new weapon found for fighting some types of breast cancer
New MRI method uses altered glucose to 'light up' pancreatic cancer
AI Cancer Detector Boasts 98% Accuracy Across 13 Types: Study
Life Experiences May Shape the Activity of the Brain’s Cellular Powerhouses
Study suggests changing the gut microbiome improves health outcomes for newly-diagnosed metastatic kidney cancer
Researchers develop scalable synthesis of cancer-fighting compounds
Nanorobot kills cancer cells in mice with hidden weapon
Reversible Molecular Changes Can Cause Cancer, Study Shows
With new results at ASCO, Enhertu once again rewrites rules of breast cancer treatment
How Google’s new AI could revolutionize medicine
NHS patients in England to be offered trials for world-first cancer vaccine
Drug that ‘melts away’ tumours hailed as ‘gamechanger’ for some bowel cancer patients
Predictive blood test hailed as ‘incredibly exciting’ breast cancer breakthrough
Tumor-associated macrophages restrict CD8+ T cell function through collagen deposition and metabolic reprogramming of the breast cancer microenvironment
New drug shows promise in easing chronic pain, study finds
“Monstrous” Discovery: Scientists Identify Key to Stopping Cancer Recurrence
Anti-PD-1 cis-delivery of low-affinity IL-12 activates intratumoral CD8+T cells for systemic antitumor responses
Scientists develop AI tool to predict how cancer patients will respond to immunotherapy
Cancer patients often do better with less intensive treatment, research shows
How Long Concussion could offer new insights into Long Covid
When plant foods are ultra-processed, the health benefits disappear
'Cutting the cable' between CD8+ T and T regulatory cells enhances checkpoint immunotherapy
Immunological synapse formation between T regulatory cells and cancer-associated fibroblasts promotes tumour development
Mass General Cancer Center Researchers Identify Gene That Helps Cancer Cells Spread Throughout the Body
‘Unusual’ cancers emerged after the pandemic. Doctors ask if covid is to blame.
Cancer Treatment Breakthrough: Researchers Develop Less Toxic, More Effective Chemotherapy
Mutation Mystery Solved: Why Lung Cancer Treatments Often Fail in Non-Smokers
Gut microbes linked to fatty diet drive tumour growth
Proteins in blood could provide early cancer warning ‘by more than seven years’
Pan-cancer proteogenomics characterization of tumor immunity
Metformin Unveils Its Hidden Talent in Cancer Prevention
Assassin Gene Discovery Shifts Cancer Treatment Paradigms – “Very Unexpected Finding”
Scientists develop new targeted therapeutic strategies to fight liver metastasis
Unlocking Cancer’s Code: Johns Hopkins Researchers Reveal How Cells Go Rogue
Newly identified biomarkers may warn of cancer 7 years before symptoms set in
Glioblastoma Drug Resistance Pathway Identified
New study shows how cancer cells exploit the immune system
These 3 Strategies Can Improve Outcomes For Cancer Patients
New Vaccine “Booster” Found To Promote Powerful Anti-Tumor Immunity
Natural killer cells: harnessing Nature’s senolytic
Cancer trial sites are growing, but poor performance is, too: report
7 Years Before Diagnosis – Oxford Scientists Discover Key to Early Cancer Detection
Cancer researchers discover optimal cancer-killing T cells
New approach uses 'cloaked' proteins to deliver cancer-killing therapeutics into cells
Ancient Egyptians tried to treat cancer 4,000 years ago, cut-marked skull indicates
New Research Links Tattoos to Increased Risk of Cancer
Can obesity cause cancer? Examining the connection between obesity and cancer
Turning tumours against themselves
Chinese scientists’ discovery could improve pancreatic cancer patients’ survival rate
Cancer signs could be spotted years before symptoms, says new research institute
Obesity-related T cell dysfunction impairs immunosurveillance and increases cancer risk
‘This is the holy grail of cancer therapy.' New device in OC hospital targets cancerous tumors
Scientists Destroy 99% of Cancer Cells in The Lab With Vibrating Molecules
The five-step wellness model that really works – and the psychology behind it
Immune Response to Investigational RNA Vaccine for Pancreatic Cancer Continues to Correlate with Clinical Benefit
Medication overuse in oncology: current trends and future implications for patients and society
Unraveling the Rapid Aging Mystery Behind Early-Onset Cancers
Hopes rise for mRNA cancer vaccine after Moderna trial shows promise
AACR: Breast Cancers Have DNA Repair Crutch Kicked Away by Saruparib
Improving drug development with a vast map of the immune system
Blood test may improve detection of pancreatic cancers
Sister Cells Reveal Cancer’s Fate
Metformin may help the immune system better identify breast cancer cells
Revolutionizing Glioblastoma Treatment
Column: A cancer survivor’s advice: research, persistence and second opinions
Antibiotics reveal a new way to fight cancer
EPA Finalizes New Standards for Cancer-Causing Chemicals
A multi-cancer early detection blood test using machine learning detects early-stage cancers lacking USPSTF-recommended screening
Accelerated aging may be a cause of increased cancers in people under 55
Poor diet increases cancer risk: Scientists uncover missing link
I’m a breast cancer surgeon and survivor – this is what I want women to know
Cancer cell metabolism and antitumour immunity
Detecting cancer in minutes possible with just a drop of dried blood and new test, study hints
Cancer patients can now be 'matched' to best treatment with DNA and lab-dish experiments
The gut microbiome-prostate cancer crosstalk is modulated by dietary polyunsaturated long-chain fatty acids
Vitamin D Boosts Gut Bacteria for Cancer Immunity
Blocking gene may halt growth of breast cancer cells
‘Real hope’ for cancer cure as personal mRNA vaccine for melanoma trialled
Cancer Can Form without Genetic Mutations, Just Epigenetic Changes
BGU researchers use novel chemo delivery to kill colorectal cancer liver metastases
Transient loss of Polycomb components induces an epigenetic cancer fate
KETO SUPPLEMENT MAY IMPROVE IMMUNOTHERAPY FOR PROSTATE CANCER
Unknown risk factor linked to high rates of kidney cancer, DNA study finds
Researchers discover how immune B cells hunt down cancer around the body
Scientists Discover a Missing Link Between Diet And Cancer Risk
Nanoparticles Penetrate Blood-Brain Barrier to Treat Cancer
New Research Links Popular Hormone Drugs to Brain Tumors
What We Get Wrong About Manifesting
Nearly half of cancer patients have medical debt, despite most being insured
Breakthrough in Immunotherapy for Brain Cancer
Scientists discover how deadly skin cancer evades the human immune system
Comparing side effects after prostate cancer treatment
Development of NK cell-based cancer immunotherapies through receptor engineering
Study shows good sleep stimulates the immune system
Deadly brain cancer shrinks after CAR-T therapy — but for how long is unclear
‘Dramatic’ inroads against aggressive brain cancer
A simple blood test can detect colorectal cancer early, study finds
How a natural compound from sea squirts combats cancer
Prime Editing Helps Scientists Screen the Effects of Cancer Mutations
Scientists identify Achilles heel of lung cancer protein
Breast cancer drug may help thousands more women than previously thought
Senescence drives immunotherapy resistance by inducing an immunosuppressive tumor microenvironment
Enhanced screening could significantly decrease cervical cancer cases and deaths
First cell therapy for solid tumours heads to the clinic: what it means for cancer treatment
Heart Problems: Investigating the Cardiac Side Effects of Cancer Treatments
Cancer in Iowa: What role does agriculture play in Iowa’s high cancer rates?
Cervical cancer rates are climbing among low-income women. Here’s why.
Unlocking mRNA’s cancer-fighting potential
How does a cancer vaccine work?
Comparing side effects after prostate cancer treatment
Magnesium's pivotal role in slowing aging's impact
Pan-cancer proteogenomics characterization of tumor immunity
5 Best Hospitals for Cancer Treatment in the US
Hand-held Test for Breast Cancer Uses Your Saliva and Gives Accurate Readings in 5 Seconds
Lipid Nanoparticles Engineered to Target Lung Cells Reduce Tumor Size in Mice
Can you prevent cancer with lifestyle changes?
The doctor behind the next big thing in cancer treatment
Stress Plays Key Role in Cancer Spread
Gut bacteria linked to colorectal cancer in young people
'Olive oil' drug shows early promise for some brain cancer patients
An immunogenetic basis for lung cancer risk
Can you prevent cancer with lifestyle changes?
Cancer cure hopes as Nobel Prize-winning oncologist shares clinical trials successes
TIL therapies: the impact on cancer research
A watershed moment for cancer therapies has arrived
Post-cure worry: Dying cancer cells can induce cancer in healthy cells, finds study
Tumor Heterogeneity: Navigating the Next Frontier in Cancer Research
SLC38A2 and glutamine signalling in cDC1s dictate anti-tumour immunity
How a novel drug may improve survival rate for people with some types of lung cancer
Revolutionizing Cancer Treatment: The Power of Personalized Vaccines
Aging With Optimism: Yale Study Links Positive Attitudes to Cognitive Restoration
Drug combination provides a one-two punch attack against colorectal cancer
Researchers reveal how cells rewrite their fate
Why Is Colorectal Cancer Rising Rapidly among Young Adults?
Cancer as a Metabolic Disorder
Stress Neurons Mapped the Brain, Exposing Estrogen Link
SLC38A2 and glutamine signalling in cDC1s dictate anti-tumour immunity
Researchers discover a new mechanism of cancer immune defense
Study gives new insight into how cancer metastasizes to the brain
Bowel cancer breakthrough after immune system find
Common blood thinner may double as cancer therapy
Cancer's origin story features predictable plot line, researchers find
Are we on the verge of vaccinating against CANCER? Another promising shot treats two of the deadliest and fastest-rising forms of the disease, early study shows
Scientists uncover a startling -- and exploitable -- coordination of gene expression in tumors
Sugar and cancer – what you need to know
Team identifies key driver of cancer cell death pathway that activates immune cells
Scientists Discover an Epigenetic Key That Unlocks Common Deadly Cancers
Restoring tumor immunogenicity with dendritic cell reprogramming
Preoperative Treatment of Locally Advanced Rectal Cancer
For uninsured people with cancer, securing care can be like spinning a roulette wheel
Scientists develop pill that destroys solid cancer tumours in early research
Pancreatic Cancer Vaccine Shows Promise In Small Trial
Protection against Cancer with Medicinal Herbs via Activation of Tumor Suppressor
Dietary Supplement Could Improve Breast Cancer Treatment
Groundbreaking Israeli cancer treatment has 90% success rate
Newly Discovered T-Cells Could Rid Late-Stage Cancer Patients of Tumors
Mannose: A Sweet Option in the Treatment of Cancer and Inflammation
Tissue-regeneration program underlies lung-cancer suppression
Cruciferous vegetables as a treasure of functional foods bioactive compounds: Targeting p53 family in gastrointestinal tract and associated cancers
Homeopathic Treatment as an Add-On Therapy May Improve Quality of Life and Prolong Survival in Patients with Non-Small Cell Lung Cancer: A Prospective, Randomized, Placebo-Controlled, Double-Blind, Three-Arm, Multicenter Study
Homeopathic Regimen effective in treating side effects of Chemo and Cancer Surgery
Post-cancer treatment of Condurango 30C, traditionally used in homeopathy, ameliorates tissue damage and stimulates reactive oxygen species in benzo[a]pyrene-induced lung cancer of rat
Benefits of Homeopathic Complementary Treatment in Patients With Breast Cancer: A Retrospective Cohort Study Based on the French Nationwide Healthcare Database
Feasibility of Homeopathic Treatment for Symptom Reduction in an Integrative Oncology Service
Upping levels of key nutrient maintains immune cell response to cancer
Common Seizure Drug Blocks Deadly Brain Cancer Growth
Fundamentals of cancer metabolism
A new target to slow down ageing and reduce blood cancer risk
Parthenolide, a feverfew-derived phytochemical, ameliorates obesity and obesity-induced inflammatory responses via the Nrf2/Keap1 pathway
Medicine is plagued by untrustworthy clinical trials. How many studies are faked or flawed?
More than bad luck: Cancer and aging are linked to replication-driven changes to the epigenome
Scientists Discover Secret Link Between Two Key Cancer Hallmarks
Green tea compound aids p53, 'guardian of the genome' and tumor suppressor
How a controversial US drug policy could be harming cancer patients worldwide
Inside Job – Scientists Discover Entirely New and Unexpected Killer of Immune Cells Lacking “Self”
New research discovers new cause of cancer coming from inside us
Despite recent improvement, childhood cancer diagnoses are more common than 15 years ago, study finds
Studies Test CAR T-Cell Therapies Designed to Overcome Key Limitations
90% of patients respond to new blood cancer treatment in trial
Anticancer properties of bromelain: State-of-the-art and recent trends
It Turns out that p53 is Destroyed in a Whole New Way
Study shows the benefit of harnessing the body's own immune cells to fight brain cancer
Hidden Linkages: Scientists Find Mind-Body Connection Is Built Into Brain
Neurological Signals and Cancer
Asparagine restriction enhances CD8+ T cell metabolic fitness and antitumoral functionality through an NRF2-dependent stress response
Alternative therapies for cancer
Scientists Discover New Way To Boost the Immune System
Researchers Discover a New Mechanism of Cancer Immune Defense
Sugar-Sweetened Drinks Linked to Liver Cancer
Scientists genetically engineer bacteria to detect cancer cells
Tiny antibodies hold big promise for cancer treatment
Traditional medicine has a long history of contributing to conventional medicine and continues to hold promise
Nanotechnology's triple threat: Advancing precision cancer treatment
Prostate cancer: An emerging surgical alternative shows promise in older men
Licorice compound suppresses ‘silent killer’ pancreatic cancer, Hong Kong study finds, paving way for improved treatment
Surprising Finding: Scientists Discover New, Unexpected Mechanism of Cancer Cell Spread
First-of-its-kind cancer drug targets mechanism that causes metastasis
Researchers discover how malignant melanoma eludes immune cells
Potent anti-cancer therapy created using 'click chemistry'
Cancer imaging: Scientists achieve significant progress in metabolic MRI
New Insights Into Uncharted Territory – Scientists Discover an Enzyme Unexpectedly Playing a Role in the Spread of Leukemia
Daily Vitamin D Consumption May Reduce Cancer Mortality
Fecal transplants safe and effective in treating advanced melanoma, clinical trial shows
Why Does Eating Foods Cooked at High Temperatures Increase Cancer Risk? Stanford Scientists Discover Surprising New Reason Why
How a novel drug may improve survival rate for people with some types of lung cancer
Revolutionizing Cancer Treatment: The Power of Personalized Vaccines
Red meat, sugar may be causing colorectal cancer in younger adults
Researchers find possible cause for chemoresistance in bowel cancer
Muscle contractions release chemical signals that promote brain network development
Lung cancer pill cuts risk of death by half, says ‘thrilling’ study
Stanford Medicine Reveals: Tiny DNA Circles Defying Genetic Laws Drive Cancer Formation
New Gel Treatment Wipes Out Deadly Brain Cancer in Mice – Offers Hope For Defeating Glioblastoma in Humans
Facing cancer? Here's when to consider experimental therapies, and when not to
Adopting a Mediterranean diet has the same benefit as 4,000 extra steps per day
Research finds alternating estrogen and anti-estrogen therapies effective in treating metastatic breast cancer
4 Small but Mighty Mindfulness Tactics
'Red meat, sugar may cause colorectal cancer in young people'
Gut Microbiome Changes Linked to Precancerous Colon Polyps
UK trials for cancer breath tests reach final stages
Beware the Splice of Life: This Killer Protein Causes Pancreatic Cancer
Cancer and your mental health: Tips from an expert in oncology and psychiatry
Prostate cancer shouldn’t be a death sentence. But for a startling number of U.S. males, it is
Do I have cancer? 10 common pre-cancer signs to know
The Surprising Impact of Time on Cancer Diagnosis and Treatment
Inducing Self-Destruction in Glioblastoma Brain Cancer
Can a daily multivitamin slow cognitive aging? Maybe
An mRNA vaccine to treat pancreatic cancer
9 Research-Backed Ways to Connect With Others
New Harvard-Developed AI Predicts Future Pancreatic Cancer Up to Three Years Before Diagnosis
Completely new mechanism behind some cancers discovered
Homeopathic medicines for adverse effects of cancer treatments
Is There Good Scientific Evidence for Homeopathy?
Alternative Cancer Treatments
PFAS Promote Migration of Lab-Grown Cancer Cells
Dr. Kukreja on kidney cancer research presented at SUO 2023
Immunopeptidomics offer new hope in cancer research
Patients with metastatic colorectal cancer may continue benefiting from immunotherapy after treatment discontinuation
The Side Effect Roulette of Cancer Treatment
Fighting brain tumors with the help of viruses and molecules
NIH researchers develop approach that could help supercharge T-cell therapies against solid tumors
New Research Shows How Cancer Rewires a Key Immune Pathway To Spread
Discovery unveils promising anticancer drug targeting KRAS protein
Common chemotherapy drugs don't work like doctors thought, with big implications for drug discovery
Mechanics of breast cancer metastasis discovered, offering target for treatment
60-year-old drug can resensitize treatment-resistant brain cancer cells
“Mind-Blowing” Cancer Discovery – Common Chemotherapy Drugs Don’t Work Like Doctors Thought
“Game Changer for Vitamin D” – Supplementation Found To Improve Cancer Survival
Innovative antibody approach targets deep-seated cancer mutations
New cancer drug shows promise targeting genetic weakness in tumors
Discovery unlocks potential new arsenal to target leukemia and other cancers
Epigenetic regulation during cancer transitions across 11 tumour types
NIH researchers develop approach that could help supercharge T-cell therapies against solid tumors
New quick, cheap blood test may detect cancer before symptoms appear
A known environmental hazard can change the epigenetics of cells
Study shows that smoking 'stops' cancer-fighting proteins, causing cancer and making it harder to treat
Scientists Uncover Structural Secrets of Key Cancer Protein
Scientists Discover Ancient Anti-Cancer Mechanism: DISE
Scientists engineer potent immune cells for 'off-the-shelf' cancer immunotherapy
Targeting of intracellular oncoproteins with peptide-centric CARs
Brain and body are more intertwined than we knew
Working under the sun causes 1 in 3 deaths from non-melanoma skin cancer, say WHO and ILO
Vitamin B5 supports MYC oncogenic metabolism and tumor progression in breast cancer
Lung cancer pill shows 'earth-shattering' results in 5-year study: 'An optimistic time'
Gastric cancer biomarker nearly 90% accurate, even in early stages
Survivor reflects on living with cancer and the ambiguity of remission
Preclinical research points to a promising new treatment option for pancreatic cancer patients
Pancreatic cancer discovery opens the door for new clinical trial
Discovery of an antibody that stimulates the immune system to eliminate cancer cells
No. 1 life regret of dying patients: I see it ‘all the time,’ says psychology expert—what to do ‘before it’s too late’
Fewer Side Effects – A New Treatment Method for Pancreatic Cancer
Nutrient found in beef and dairy improves immune response to cancer: Study
New tech screens & identifies drugs capable of stopping melanoma spread
Scientists Find Anesthetic Kills Cancer Cells Via Unique Mechanisms
Scientists Find 'Kill Switch' That Activates Cancer Cell Death in The Lab
Scientists Uncover Potentially Serious Side Effect of Common Cancer Drug
Beefing Up Immunity: Nutrient Found in Meat and Dairy Improves Cancer Defense
Which foods may increase, and which may lower bowel cancer risk?
Scientists Destroy 99% of Cancer Cells in The Lab Using Vibrating Molecules
New form of immunotherapy under investigation for cancer that resists conventional T cell therapies
Breakthrough in nitrile activation is promising pathway for anticancer precursor synthesis
Revolutionary nanodrones enable targeted cancer treatment
Scientists Uncover Cancer’s “Death Star” – Secret Vulnerabilities Revealed
Scientists unlock the potential of Myeloid cells to cure pancreatic cancer
Beans beneficial for patients with history of colorectal neoplasia
One person a minute will be diagnosed with cancer by 2040, charity warns
Dna Trick Makes Resistant Cancer Vulnerable to Chemo
Inhalable sensors could enable early lung cancer detection
When bad cells go good: Harnessing cellular cannibalism for cancer treatment
The 'mosquito effect': How tumor cells outwit the body's immune system
Brain Cancer Cells Imitate Neurons, Evading Treatment Strategies
“Glob of randomness” linked to 75% of cancers reined in by novel peptide
MIT experts develop AI models that can detect pancreatic cancer early
Research reveals an immune cell that can attack cancer
Scientists Find “Key” To Potential Breast Cancer Prevention, Treatment
Scientists identify critical protein complex for targeted cancer treatment
New Vaccine May Help Stop Recurrence of Certain Pancreatic, Colorectal Cancers
More than 900 common chemicals linked to breast cancer risk: Study
Scientists Use Organoid Model to Identify Potential New Pancreatic Cancer Treatment
New mechanism with potential to boost checkpoint-blocking cancer immunotherapies identified
Energy-starved breast cancer cells consume their surroundings for fuel
Researchers uncover on/off switch for breast cancer metastasis
Standing united: When immune cells join forces, cancer therapy is more effective
Cervical cancer increasing in women in their 30s and 40s, new report finds
Cancer vaccine with minimal side effects nearing Phase 3 clinical trials
Over 900 chemicals linked to greater breast cancer risk by researchers
Chemotherapy becomes more efficient when senescent cells are eliminated by immunotherapy, shows study
FDA warns of secondary cancer risk tied to CAR-T therapies that treat cancer
Metabolic heterogeneity in cancer
Researchers May Have Cracked a Cancer Enigma
Study suggests changing to a healthier diet could add ten years to your life
One protein is key to the spread of lung cancer: New study finds a way to stop it
The Pancreatic Puzzle: Cracking the Code of Cancer’s Immune Secrets
5 counterintuitive ways scientists are approaching cancer research
Once-a-day pill for stubborn cancer delivers a 62.5% positive response
'Useless' Organ That Doctors Often Remove Could Actually Fight Cancer
Manipulation of gut microbiota with flaxseed could reduce breast cancer risk, research suggests
A new connection between the gut microbiota and prostate inflammation in aging men
New compound could lead to therapeutics that selectively kill cancer cells
Why one particular diet is found to be the best year after year
New drug triggers "calcium storm" to choke cancer cells to death
Getting fitter can reduce prostate cancer risk by 35%, study finds
The anti-cancer potential of sRNAs isolated from different mushroom species
Study observes rapid immune response in individuals switching to vegan and keto diets
A one-molecule immune evasion system: New discovery could land one-two punch against cancer
Researchers discover epigenetic status determines metastasis
Response to tumor-infiltrating lymphocyte adoptive therapy is associated with preexisting CD8+ T-myeloid cell networks in melanoma
New potential immunotherapies for pancreatic cancer
The breast cancer burden in lower income countries is even worse than we thought
New vaccine may be potential off-the-shelf treatment for pancreatic, colorectal cancer
Model tumors identify best drugs for bowel cancer before treatment
Global cancer cases will jump 77% by 2050, WHO report estimates
NIH analysis reveals a significant rise in use of complementary health approaches, especially for pain management
How does cancer spread to other parts of the body?
Immune Cells’ “Killer Instinct” Can Be Reawakened in Tumors
Frustrated by the constraints of Earth, a team of California scientists took tumor research to space—and may have discovered a ‘kill switch’ for cancer
How cancer hijacks the nervous system to grow and spread